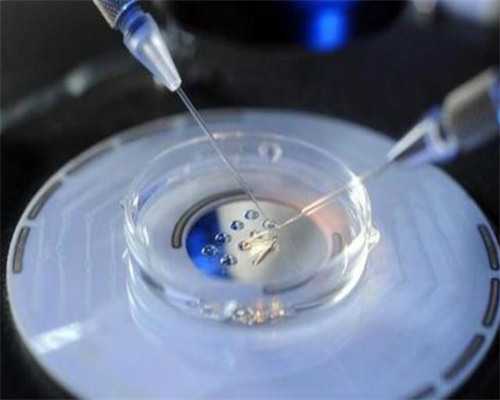
生育新希望：解析承德地区辅助生殖技术与费用

想要了解承德哪里能做试管婴儿,或者市妇幼保健院是否提供相关服务?本文为您梳理了本地可进行辅助生殖技术的医院信息。承德市妇幼保健院和承德市中心医院均已获得开展辅助生殖技术的资质,详细情况如下:
承德地区试管婴儿技术与费用解析
在承德,承德市妇幼保健院是目前唯一能提供试管婴儿服务的医疗机构。具体的代生价格表会因女性的身体状况以及所选用的试管婴儿技术(第一代、第二代、第三代)而有所不同。第一代试管婴儿(IVF)主要针对输卵管堵塞等情况,费用大约在1-3万元。第二代试管婴儿(ICSI),适用于精子质量较差的男性,费用约为2-6万元。第三代试管婴儿,即胚胎植入前基因诊断,用于筛查健康胚胎以防止遗传病,费用则在6-10万元左右,但请注意,出于政策原因,不能选择性别。综合来看,在国内进行一个常规的试管婴儿周期(不含第三代技术)费用大约在3-5万元。代怀套餐的选择也会影响最终的费用。
试管婴儿成功率考量
试管婴儿的成功率与个体身体状况密切相关。良好的卵子和精子质量、积极放松的心态都有助于提高成功率。虽然有部分数据可能作为参考,但关键还是在于个人身体条件和胚胎质量。年轻、身体健康的夫妇通常成功率更高。国内生殖中心的统计数据仍在完善中,国际公认的平均成功率水平可供参考。
高龄二胎备孕与试管婴儿考量
对于36岁高龄的二胎备孕女性,自然受孕几率较低,试管婴儿成为一种选择。国内并非所有城市都开展试管婴儿技术,如广水当地便无此条件,需前往武汉、宜昌、十堰等地。代生公司提供的服务和技术是影响成功率和费用的重要因素。高龄女性常被建议进行第三代试管婴儿,费用相对较高,一个疗程基本在3-5万元,若需进一步尝试,则需预留额外费用。代生技术的选择也需慎重考虑。
哪里能做三代试管婴儿?
国内能进行第三代试管婴儿的医院主要集中在北京、上海、广州等一线城市,这些地区知名度和成功率相对较高。例如,广东省拥有10家可开展三代试管技术的医院,北京市有3家。其他热门医院包括山东附属生殖医院、湘雅医院等。第三代试管婴儿的费用包含促排卵、取卵/取精、胚胎筛查与培养、移植等环节,通常在8-10万元左右,具体费用因个体差异和用药方案而异。代生助您实现生育梦想。
(本文部分图片及内容来源于网络,如有侵权请联系删除。)